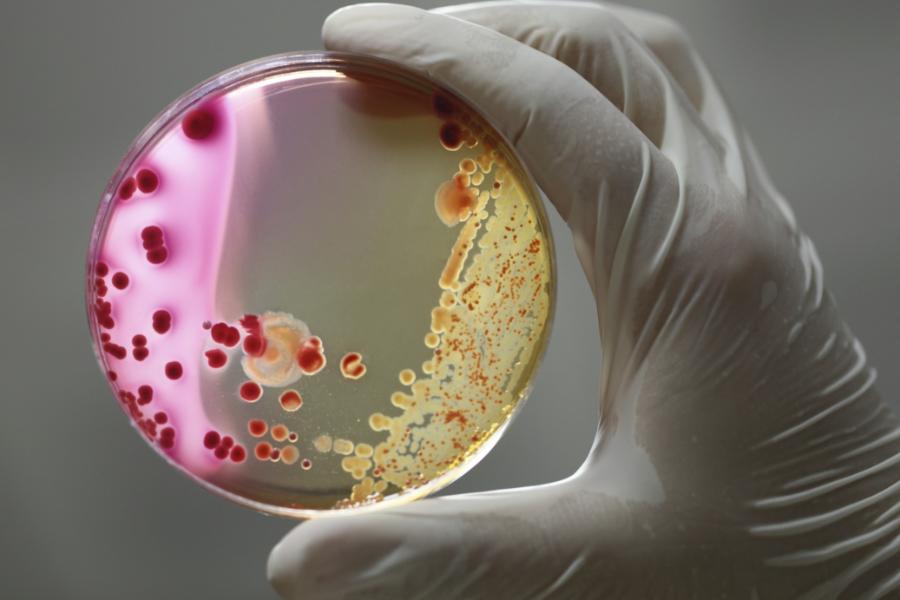

Зоология - наука о животных
Список вопросов теста
Вопрос 1
Основателем науки о животных является:
Варианты ответов
- Теофаст
- Аристотель
- Гиппократ
- Гален
Вопрос 2
Поведение животных изучает:
Варианты ответов
- экология
- этология
- физиология
- эмбриология
Вопрос 3
Рыб изучает:
Варианты ответов
- орнитология
- малакология
- акарология
- ихтиология
Вопрос 4
Профессиональный животновод, который занимается обеспечением оптимальных условий разведения, кормления и содержания сельскохозяйственных животных для получения от них наибольшего количества высококачественной продукции при наименьших затратах труда и средств.
Варианты ответов
- зоотехник
- ветеринар
- кинолог
- охотовед
Вопрос 5
Как называется раздел биологии, объектом изучения которого является изображённый на фотографии объект?
Варианты ответов
- генетика
- микробиология
- эмбриология
- палеонтология
Вопрос 6
Как называют специалиста-зоолога, объектом изучения которого являются изображённые на фотографии животные?
Варианты ответов
- мирмеколог
- герпетолог
- физиолог
- кинолог
Вопрос 7
Как называется раздел биологии, объектом изучения которого являются изображённые на фотографии объекты?
Варианты ответов
- зоология
- герпетология
- орнитология
- териология
Вопрос 8
Специальность учёного, занимающегося лечением домашних животных, называется

Варианты ответов
- зоотехник
- ветеринар
- селекционер
- агроном
Вопрос 9
Как называют профессию, объектом разведения и изучения которой являются изображённые на фотографии животные?

Варианты ответов
- кинолог
- пчеловод
- ветеринар
- энтомолог
Вопрос 10
Как называют специалиста-зоолога, объектом изучения которого является изображённое на фотографии животное?

Варианты ответов
- териолог
- энтомолог
- орнитолог
- микробиолог
Вопрос 11
Как называют специалиста-зоолога, объектом изучения которого является изображённое на фотографии животное?

Варианты ответов
- орнитолог
- энтомолог
- герпетолог
- гельминтолог
Вопрос 12
Как называется раздел биологии, объектом изучения которого является изображённый на фотографии объект?

Варианты ответов
- гельминтолог
- герпетолог
- энтомолог
- ихтиолог
Вопрос 13
Как называется раздел биологии, объектом изучения которого является изображённый на фотографии объект?

Варианты ответов
- ботаника
- вирусология
- зоология
- бактериология
Вопрос 14
Как называют специалиста-зоолога, объектом изучения которого являются изображённые на фотографии животные?

Варианты ответов
- энтомолог
- териолог
- герпетолог
- орнитолог
Вопрос 15
Как называют специалиста−зоолога, который занимается изучением жизнедеятельности организма животных?

Варианты ответов
- физиолог
- герпентолог
- кинолог
- мирмеколог
Вопрос 16
Как называют профессию, объектом разведения и изучения которой являются изображённые на рисунке животные?

Варианты ответов
- пчеловод
- энтомолог
- ветеринар
- кинолог
Вопрос 17
Как называется раздел биологии, объектом изучения которого являются изображённые на фотографии объекты?
Варианты ответов
- зоология
- микробиология
- ботаника
- вирусология
Вопрос 18
Как называется раздел биологии, объектом изучения которого являются изображённые на фотографии объекты?

Варианты ответов
- орнитология
- зоология
- териология
- герпетология
Вопрос 19
Специальность учёного, изучающего строение и функции клеток, называется

Варианты ответов
- селекционер
- анатом
- цитолог
- эмбриолог
Вопрос 20
Какая наука изучает ископаемые остатки вымерших организмов?

Варианты ответов
- палеонтология
- систематика
- генетика
- эмбриология


